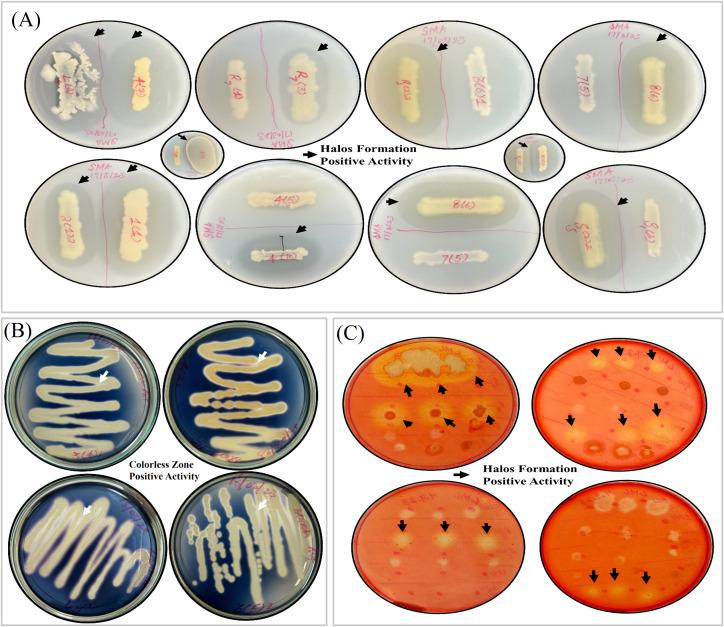
https://cdn.ncbi.nlm.nih.gov/pmc/blobs/49eb/12328432/4765c9b8a5a3/fpls-16-1622951-g004.jpg

来自乌尊戈尔森林的植物促生细菌通过种子生物引发和根系接种促进水稻生长:从不同树木根际土壤中分离和鉴定高效植物促生根际细菌菌株
Plant growth-promoting bacteria from Uzungöl forest stimulate rice growth via seed biopriming and root inoculation: isolation and functional characterization of potent PGPR strains from rhizosphere soils of different trees.
作者信息
Ishaq Saad, Belduz Ali Osman, Ceylan Esma, Senocak Aleyna Nalcaoglu, Munawar Wajeeha, Alkowlani Amir Towfiq Hasan, Terzi Rabiye, Bektas Kadriye Inan, Canakci Sabriye
机构信息
Department of Biology, Faculty of Sciences, Karadeniz Technical University, Trabzon, Türkiye.
Department of Molecular Biology and Genetics, Faculty of Sciences, Karadeniz Technical University, Trabzon, Türkiye.
出版信息
Front Plant Sci. 2025 Jul 24;16:1622951. doi: 10.3389/fpls.2025.1622951. eCollection 2025.
INTRODUCTION
Rhizobacteria naturally promote plant growth and offer a sustainable alternative to agrochemicals. In contrast to agroecosystems, forests host a diverse community of beneficial rhizobacteria that remains uncharacterized. Moreover, despite extensive research on rhizobacteria associated with cereal crops, such as rice, their efficacy in hydroponic rice cultivation still needs to be established.
METHODS
This study was aimed to isolate, characterize, and identify the potential plant growth-promoting rhizobacteria (PGPR) of different rhizospheres from Uzungöl forest situated in Trabzon, Turkey, and to evaluate their effects on the growth of rice through two distinct approaches: 1) seed biopriming to assess germination and 2) root inoculation to analyze seedling growth in a hydroponic system.
RESULTS
In total, 129 bacteria were isolated from eight different rhizospheres, and 109 exhibited indole-acetic acid (IAA) production. A strain of from the rhizosphere produced the highest (739.9 ± 251.5 µg/mL) IAA. Siderophore formation was exhibited by 16 isolates including the strains of , , and sp. Phosphate solubilization was observed only in nine isolates including the strains of and sp. Furthermore, 65 isolates including the strains of , , , and were identified as potential endogenous nitrogen-fixing diazotrophs for rice. Various isolates exhibited salt tolerance, HCN, ammonia, and hydrolytic enzyme production. Several of these PGPR strains as well as the strains of , , , , and demonstrated positive effects on rice germination or seedling growth. strain S1(E) from rhizosphere and strain SS7(5) from rhizosphere exhibited outstanding response as seed biopriming agents and root inoculants for rice.
DISCUSSION
These findings concluded that inoculation with forest-derived rhizobacteria is an effective strategy to enhance early growth of rice in soilless systems. Understanding the genetic basis of their growth promotion, coupled with large-scale field validation, could advance low-cost, sustainable rice cultivation with minimal reliance on agrochemicals.
引言
根际细菌可自然促进植物生长,为农用化学品提供了一种可持续的替代方案。与农业生态系统不同,森林中存在多种有益根际细菌群落,但尚未得到充分研究。此外,尽管对与谷类作物(如水稻)相关的根际细菌进行了广泛研究,但其在水培水稻种植中的功效仍有待确定。
方法
本研究旨在从土耳其特拉布宗的乌尊戈尔森林不同根际中分离、表征和鉴定潜在的植物促生根际细菌(PGPR),并通过两种不同方法评估其对水稻生长的影响:1)种子生物引发以评估发芽情况,2)根部接种以分析水培系统中的幼苗生长。
结果
总共从八个不同根际分离出129株细菌,其中109株表现出吲哚 - 乙酸(IAA)产生能力。来自某一根际的一株细菌产生的IAA最高(739.9 ± 251.5 µg/mL)。16株分离物表现出铁载体形成能力,包括某几株细菌。仅在9株分离物(包括某几株细菌)中观察到磷溶解现象。此外,65株分离物(包括某几株细菌)被鉴定为水稻潜在的内源性固氮菌。各种分离物表现出耐盐性、HCN、氨和水解酶产生能力。这些PGPR菌株中的几种以及某几株细菌对水稻发芽或幼苗生长表现出积极影响。来自某一根际的S1(E)菌株和来自另一根际的SS7(5)菌株作为水稻种子生物引发剂和根部接种剂表现出出色的效果。
讨论
这些发现得出结论,接种森林来源的根际细菌是在无土系统中促进水稻早期生长的有效策略。了解其促进生长的遗传基础,并结合大规模田间验证,可推动低成本、可持续的水稻种植,减少对农用化学品的依赖。